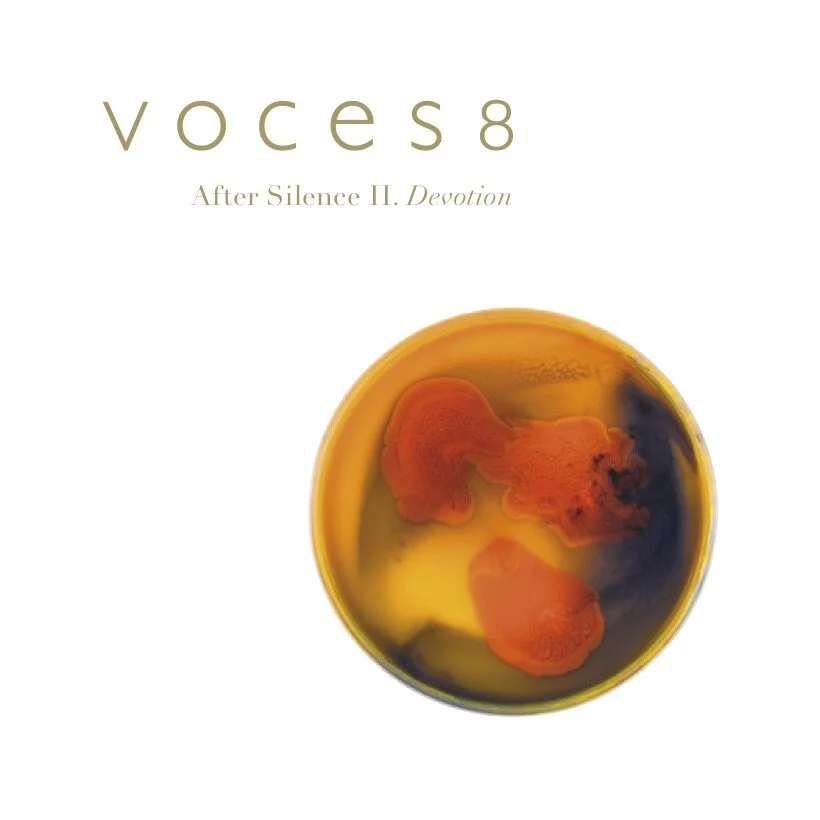

LISTEN
“The singing of VOCES8 is impeccable in its quality of tone and balance. They bring a new dimension to the word ‘ensemble’ with meticulous timing and tuning.”
Albums
“Eight beautifully integrated solo voices… Every number here has something particularly arresting within it, all supported by persuasive and committed singing. *****”
Tracks
“The slickest of the lot...fans of a cappella ought to hear this.”
Spotify
Listen on Spotify
“Be prepared to be blown away by VOCES8’s online choral festival LIVE From London.
”
VOCES8 Studios is our own Audio & Visual Studio based at our home, the VOCES8 Centre. A comprehensive kit list is available here. For more information contact Barnaby Smith
VOCES8 Records
VOCES8 Records is the recording arm of the VOCES8 Foundation and was set up in 2008 to support the aims of the Foundation. The label releases recordings from the Foundation’s professional ensembles, VOCES8, Apollo5 and Lyyra, along with other project-based recordings to support the Foundation’s ongoing work. See here for more info